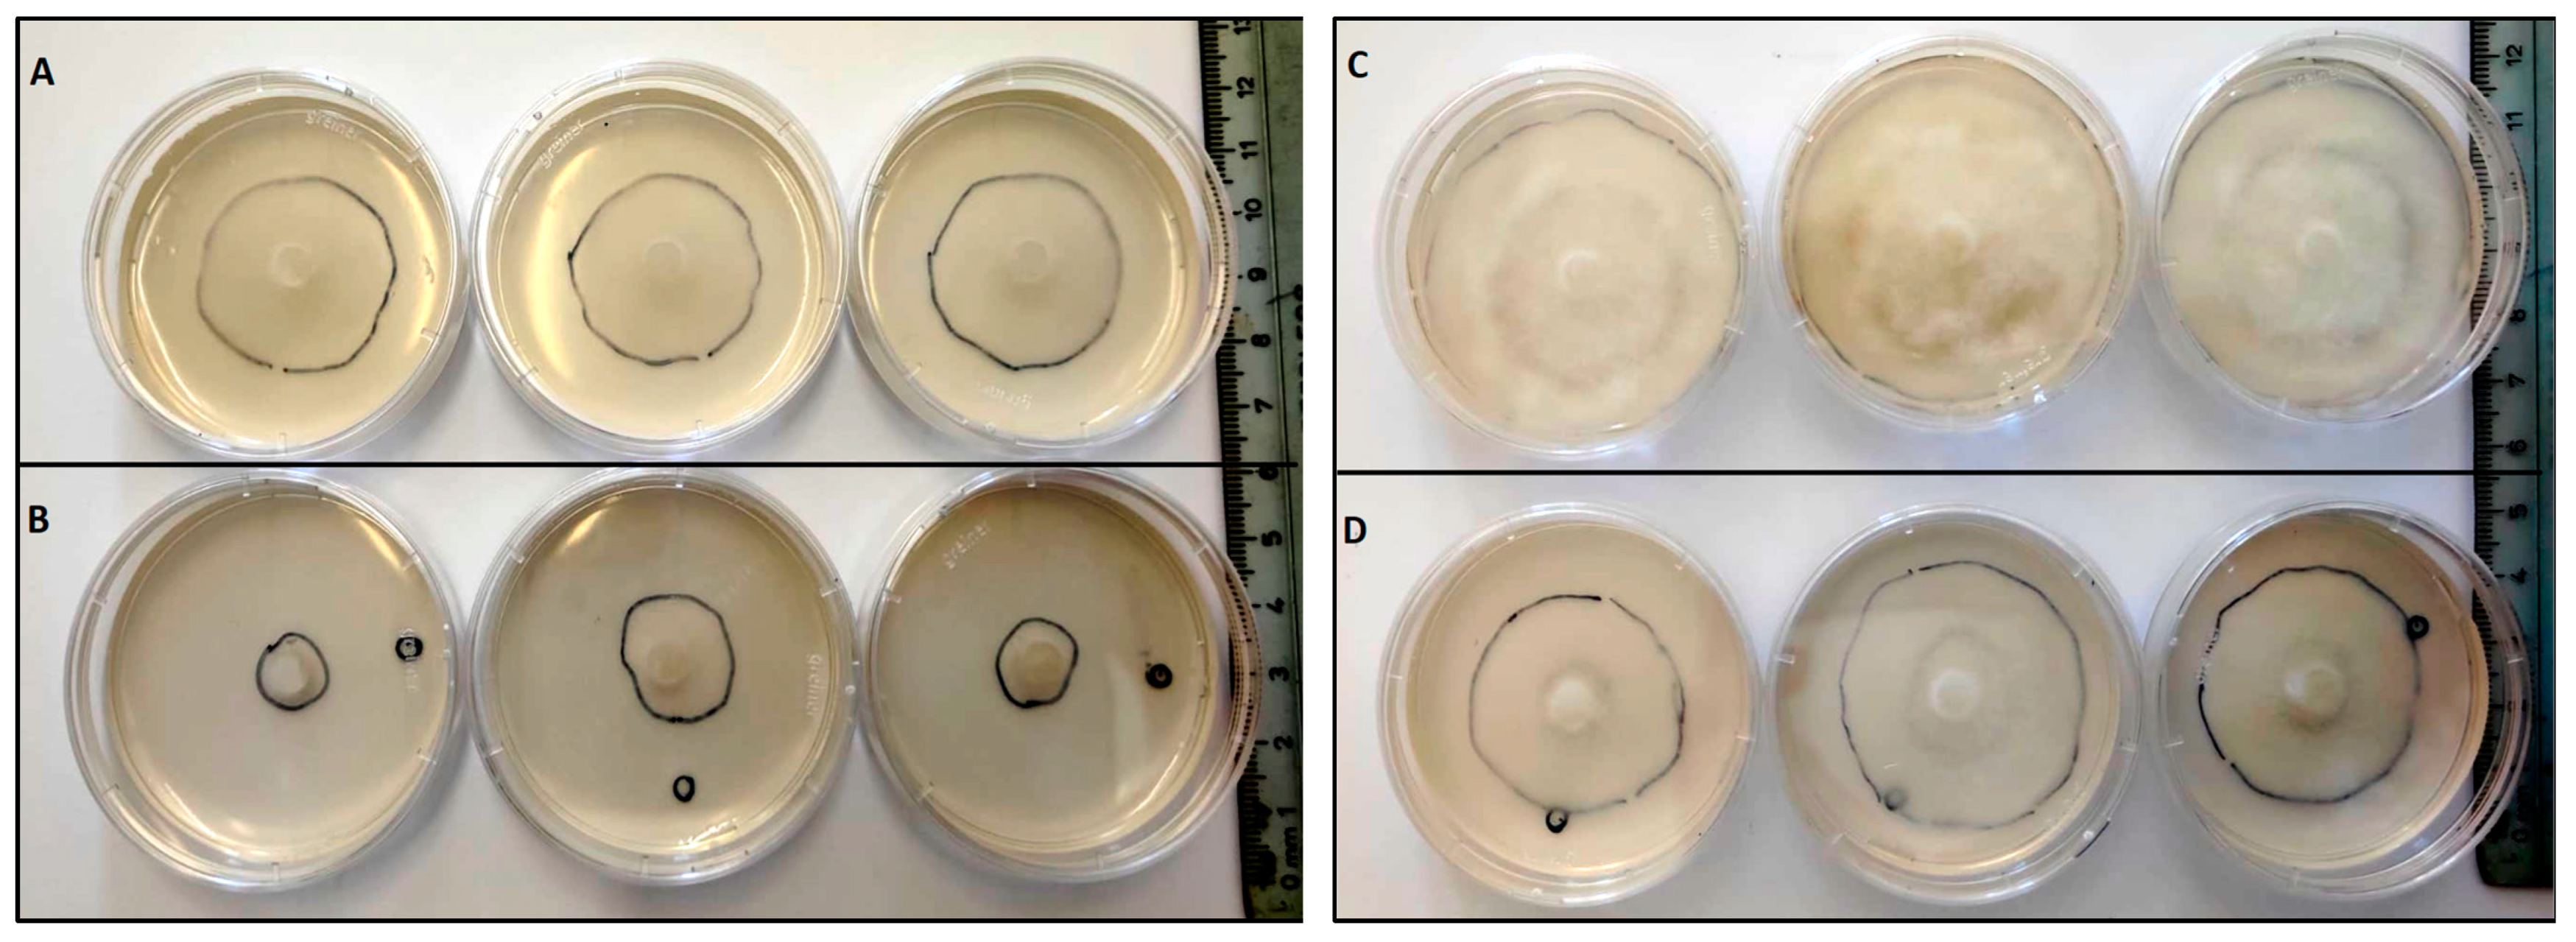
Forests 14 00785 g004

1. Introduction
The genus
Castanea belongs to the Fagaceae family, which dominates much of the hardwood forests of the Northern Hemisphere. The European chestnut (
Castanea sativa Mill.) is considered to be the only native chestnut species in Europe. This species is a multipurpose tree, that is used in the food industry for its high-quality edible fruits (nuts), in the forest industry for timber, and also for ecological and landscaping purposes [
1].
Over 100 species have been described within the genus
Phytophthora [
2]. According to many authors [
3,
4], most survive in the soil for long periods without a host and affect the parts of the plant in contact with the ground, thus causing a destruction of the root system. The impact of this group of organisms is mirrored in its name, as
Phytophthora, which means, in Greek, plant destroyer [
1,
4].
The rural economy of the northern mountainous regions of Portugal are mainly based on chestnut culture. Unfortunately, the current area and productivity per hectare are much less than the country’s potential, mainly due to root rot caused by
Phytophthora cinnamomi Rands, the main threat to chestnut orchards in Europe [
5].
Castanea sativa was severely affected and nut production has declined by 251,549 tons from 1961 to 2015 [
1,
6]. The economy of mountainous areas in the Mediterranean regions of southwest Europe mainly depends on the significant income that chestnut culture represents to the local farmers, which is sometimes the only income they can get from the land. In recent years, the persistent losses of chestnut trees to
P. cinnamomi is contributing to a decline in the population of these regions [
6].
Phytophthora cinnamomi infects the roots and after reaching the vascular tissues it continues to colonize the roots until it obstructs the xylem vessel, thus restricting root growth and interfering with water and nutrient uptake to the plant shoot. The roots and root collar start to rot, resulting in a progressive decline of the tree. The above-ground symptoms include chlorosis and wilting of leaves, dieback of branches, defoliation, and gradual decline until the tree dies [
1].
Phytophthora cinnamomi, has an extensive host range, destroying thousands of plant species worldwide and causing devastating impacts on natural ecosystems, agriculture, and forestry [
6].
The coexistence of Asian chestnut species from Japan and China (
Castanea crenata Sieb. & Zucc. and
Castanea mollissima Blume) with
P. cinnamomi (originally from the Asian tropics) lead to the development of resistance against the pathogen during the evolution process. The secretion of antifungal proteins and cell wall reinforcement are part of the constitutive defense barriers to pathogen growth in the plants that may explain the difference in resistance to
P. cinnamomi between
C. crenata and
C. sativa. Although the Asian species have proven resistant to ink disease, these species are not adapted to the Atlantic environmental conditions. Therefore, the resistance of Japanese and Chinese chestnut species to this pathogen led to their introduction in breeding programs over the last years as donors of resistance in controlled crosses [
7].
Over time, several approaches have been proposed to deal with root diseases (which affect the xylem of trees), such as the intensive application of pesticides and the selection and production of improved plant material with some disease resistance [
8]. Phosphite and metalaxyl have been the most frequently used chemicals against
P. cinnamomi. Nevertheless, the continuous use of these two chemicals has led to the development of tolerance within the pathogen [
1]. Effective biological control methods have not been developed to date [
1]. More common control approaches involve using resistant rootstocks for propagation or planting of resistant hybrids [
1]. Nevertheless, the measures and procedures have not yet been successful, mainly due to the easy development and migration of
P. cinnamomi zoospores in wet conditions, especially during rainfalls and waterlogging and because of the resistance structures that persist in the soil and are extremely difficult to eradicate [
1,
9].
A previous study identified a secreted protein with antifungal activity, Ginkbilobin2 (Gnk2), from seeds of the gymnosperm
Ginkgo biloba [
10]. Gnk2 comprises 108 amino acids as a mature protein with a plant-specific cysteine-rich motif. It functions as a lectin [
3,
11], and its carbohydrate-binding properties are tightly related to its antifungal activity. It binds with high affinity to D-mannose and with less affinity to D-glucose [
11], and both exist in the hyphal cell walls of
Phytophthora species [
12].
Our group has been studying the
C. sativa and
C. crenata root transcriptome in response to
P. cinnamomi to elucidate chestnut defense mechanisms. In a previous study [
13], we identified candidate genes differentially expressed in the roots of the susceptible species to the pathogen (
C. sativa), and the resistant one (
C. crenata) observed after
P. cinnamomi inoculation. The research demonstrated that both species recognize the pathogen attack, but only the resistant species (
C. crenata) may involve more genes in the defense response than the susceptible species (
C. sativa). RNA-seq analysis further enabled the selection of candidate genes for ink-disease resistance in
Castanea [
12]. Following the same rationale to elucidate chestnut defense mechanisms against
P. cinnamomi, our group selected the Ginkgobilobin-2-like gene (
Cast_Gnk2-like) from the transcriptomes of
C. crenata, intending to evaluate the early expression of candidate resistance genes in both species (
C. sativa and
C. crenata).
Cast_Gnk2-like was the most expressed gene and the one that best discriminates between susceptible and resistant chestnut genotypes. The highest
Cast_Gnk2-like expression registered in non-inoculation conditions suggests that
C. crenata root surroundings may be a hostile environment for fungal and fungal-like pathogens, such as
P. cinnamomi. On the other hand,
C. sativa showed a very low
Cast_Gnk2-like expression level, even after pathogen inoculation [
7].
The present work is part of an ongoing research program that aims to find solutions to this important problem regarding the Chestnut/
P. cinnamomi pathosystem in Europe. It was reported that Gnk2 inhibits the growth of pathogenic fungi such as
Fusarium oxysporum, F. culmorum, and
Candida albicans; and activates actin-dependent by inducing hypersensitive response (HR-related) plant cell death [
10]. The homology of
Cast_Gnk2-like with
Gnk2 led us to test the encoded protein against
P. cinnamomi. The present work aims to express and produce the
Cast_Gnk2-like protein for evaluation of its effectiveness on in vitro assays as a possible antagonist of the
P. cinnamomi pathogen.
2. Materials and Methods
2.1. Cast_GNK2-like In Silico Analysis
The nucleotide sequence of the C. crenata
Cast_GNK2-like transcript was obtained from the sequenced root transcriptome after
P. cinnamomi inoculation [
13]. It was annotated as a Cysteine-rich repeat secretory protein 38. After a BLASTn at NCBI and a comparison of the sequences with the highest homology, a prediction of the coding sequence and translation to the amino acid sequence was achieved. A BLAST to
Cast_GNK2-like was achieved in Uniprot [
14] to identify the proteins with higher similarity. Uniprot was also used to predict the protein families and domains of
Cast_GNK2-like by comparison with the ones of
Ginkgo biloba (GNK2),
Arabidopsis thaliana, and
C. mollissima. Signal peptides for
Cast_GNK2-like were searched using SignalP—6.0 [
15] and TargetP—2.0 [
16]. Alignment of the amino acid sequences of
Castanea mollissima Cysteine-rich repeat secretory protein 38 (A0A8J4V9V8),
Ginkgo biloba Antifungal protein ginkbilobin-2, C. crenata putative Ginkbilobin-2 protein and
A. thaliana Putative cysteine-rich receptor-like protein kinase 9, was performed using CLUSTALW [
17].
2.2. Bacterial Strains and Growth Condition
Escherichia coli bacteria strains used in this study were TOP10 and BL21 (DE3) pLysS (competent cells from Thermo Fisher Scientific Inc., Waltham, MA, USA). E. coli strains containing recombinant plasmids were cultured, at 37 °C, in LB broth medium supplemented with 100 μg/mL ampicillin or 50 μg/mL kanamycin.
2.3. Phytophthora Cinnamomi Strain
Phytophthora cinnamomi (strain PH107) was isolated at the UTAD (the University of Trás-os-Montes and Alto Douro), from Vila Real (Portugal), and it is preserved at the INIAV I.P. (Instituto Nacional de Investigação Agrária e Veterinária I.P.) in Lisbon. It is routinely cultured at 25 °C on Potato-Dextrose Agar (PDA) in Petri plates and maintained in darkness. For all the assays, a fresh culture of P. cinnamomi was prepared by transferring a small piece of mycelium from a previous culture to a new plate of PDA nutritive medium and incubated in darkness at 25 °C for 4/5 days (or maximum one week).
2.4. Plasmid Construction
The designed primers for the amplification of the
Cast_Gnk2-like coding sequence were 5′–CTCCATATGgctgacccattataccatttttgttttag–3′ and 5′– CACGGATCCctaggcatcaacaaaggggta–3′. The PCR was performed using Phusion™ High-Fidelity DNA Polymerase (2 U/µL) according to the manufacturer protocol. The vectors used for the construction were pET15b and pET28a (Novagen
®, Gujarat, India), which carry an N-terminal or an N- and C- terminal oligo-histidine tag (6x His-tags), respectively. The DNA sequence encoding
Cast_Gnk2-like was inserted into the vectors between
NdeI and
BamHI sites. Control plasmids were constructed without the
Cast_Gnk2-like fragment. It is expected to observe a protein fraction (a band in the gels) in the region of 25 kDa. The size of the
Cast_Gnk2-like coding sequence is represented in
Figure 1 (726 bp).
2.5. Protein Expression
2.5.1. Preparation of Bacterial Cellular Lysates
The cell culture was centrifuged at 4000 g for 20 min, and the pellet was resuspended in a 50 mM sodium HEPES buffer (4-(2-hydroxyethyl)-1-piperazineethanesulfonic acid), pH 7.5, containing 1 M NaCl and 10 mM imidazole (1,3-diazaciclopenta-2,4-dieno). Cells were disrupted by sonication. The cell debris was removed by centrifugation, and the supernatant was filtrated (0.45 μm) before the protein purification process.
2.5.2. Protein Purification and Electrophoresis (SDS-PAGE)
The supernatant (cell-free extract) obtained after centrifugation was applied to 5 mL Ni2+ ion chelating immobilised ion affinity chromatography column (HiTrap, GE Healthcare, Chicago, IL, USA). The column was preequilibrated with 50 mM sodium HEPES buffer, pH 7.5, containing 1 M NaCl and 10 mM imidazole. The recombinant protein, Cast_Gnk2-like, was eluted with a linear gradient of imidazole (0–300 mM) in 50 mM sodium HEPES buffer, pH 7.5, containing 1 M NaCl. Protein purity was evaluated by SDS–PAGE (sodium dodecyl sulfate polyacrylamide gel electrophoresis), performed in a Protean II xi cell (Bio-Rad, Hercules, CA, USA) at 480 V and 120 mA. The running buffer contained 25 mM Tris base, 0.2 M glycine, and 0.1% SDS. Gels were stained with Coomassie (Bio-Rad Biosafe, Hercules, CA, USA). The protein concentrations were determined using Bradford reagent (using bright blue Coomassie G-250) from BioRad utilizing bovine serum albumin (BSA) as the standard.
2.6. Western Blot
Identification of antigens recognized by serum antibodies was carried out after the separation of total antigens by SDS-PAGE and Western blotting [
18]. Following SDS-PAGE, the separated proteins were transferred to nitrocellulose sheets (Amersham
TM Protran
® Premium 0.2 µm pore size NC). The sheets were blocked with phosphate-buffered saline, pH 7.2, containing 0.3% Tween-20 (0.3% PBS-T), and washed twice. Then they were incubated with His-Tag Antibody (AD1.1.10) solution for one hour at room temperature, always in soft shaking. After washing them three times with 0.3% PBS-T, the secondary antibody solution (m-IgGκ BP-HRP) was added for one hour in the same conditions. After that, another three washes with 0.3% PBS-T were done.
Immunoreactive spots were detected with a chemiluminescence-based kit (Amersham Pharmacia Biotech, Amersham, UK). Before immunodetection, the nitrocellulose membranes were stained with 0.2% w/v Ponceau S in 3% w/v trichloroacetic acid for 3 min.
2.7. Cast_Gnk2-like In Vitro Antagonist Activity against P. cinnamomi
Two types of antagonist assays were performed. One of them was done in 60 mm diameter Petri dishes to evaluate P. cinnamomi mycelium development with different Cast_Gnk2-like pure protein concentrations (0.2 and 0.5 mg/mL). Briefly, in the solid medium assay, mycelial discs of 5-mm diameter were taken from the margins of approx. 1-week-old P. cinnamomi cultures and placed on new PDA medium plates. Different protein concentrations were tested and first spread in all the plates homogeneously, forming a thin film. The Petri plates were left for 25 min inside the flow chamber to dry the liquid above the solid medium before inoculation with P. cinnamomi. Different volumes of pure protein were also tested (100, 250, and 500 µL/plate). Control PDA medium Petri plates contained buffer solution without Cast_Gnk2-like protein. The plates were kept at 25 °C in darkness, and the growth of P. cinnamomi was evaluated during the following days of incubation (mainly 24, 48, and 72 h). Photographs of the mycelial growth were taken and the area determined with Image J software (Version 1.51r, NIH, Rockville, MD, USA). The second assay was performed in a liquid culture using Potato-Dextrose medium (50 mL) in Erlenmeyer flasks. Mycelial discs (10 discs of 5-mm diameter) were added to each flask and growth of P. cinnamomi was evaluated by determining mycelial dry weights (g) after two days of shaking (180 rpm) at 25°C. Controls were buffer solution without Cast_Gnk2-like protein.
2.8. Statistics
For fungal inoculation experiments, at least 10 biological replicates were used for each test, and the experiments were performed 3 times with similar results. The results shown in the pictures are examples from representative samples of n repetitions. The area of P. cinnamomi mycelia growth expressed in mm2 was determined. Graph Path software was used to prepare the figures, and the results are shown as means ± SEM. Data were analyzed by appropriate t-test or ANOVA followed by post hoc comparisons by Tukey or Dunnett’s test.
4. Discussion
This work is part of the ongoing research program that aims to find solutions to the health problem regarding European chestnuts (
C. sativa) and the pathogen
P. cinnamomi [
1]. This program involves an integrated approach using genomics, phenomics (precision phenotyping), transcriptomics, association mapping of traits, and histopathology, to reveal the mechanisms of the resistance of Asian species to infection by
P. cinnamomi, and to transfer the knowledge for the improvement of resistance of European chestnut [
7,
9,
13,
18,
19,
20,
21,
22]. The program is supported by a breeding program initiated in 2006, based on controlled crosses, from which segregated hybrid populations were obtained with the selection of new genotypes with improved resistance to
P. cinnamomi, which soon will be disclosed to the market to be used as rootstocks. The research and breeding efforts made in the last decades are having a positive impact since chestnut production in Europe has been increasing since 2015 for the first time in many decades. Nevertheless, more research and techniques are needed to overcome the decline of European chestnut [
1].
The secretion of antimicrobial proteins in plants and the reinforcement of the cell wall are part of constitutive defense barriers against pathogens [
7,
23]. Also, the secretion of compounds toxic to pathogens is an effective chemical defense mechanism in plants. According to Santos et al. (2017) [
7], Ginkbilobin-2 (Gnk2) is the most expressed protein, secreted by
Ginkgo biloba seeds [
24], and it was shown to possess antifungal activity. In a previous study where we used a histological approach to observe the responses exhibited by susceptible and resistant chestnuts under
P. cinnamomi infection, we found that the early accumulation of phenolic-like compounds in cell walls was observed 0.5 h after inoculation in
C. crenata root tissues which may prevent the spread of hyphae [
9]. In the chestnut species resistant to
P. cinnamomi,
C. crenata, the Ginkgobilobin-2-like gene (isolated from transcriptomes of
C. crenata [
13] showed relevant expression constitutively and upon
P. cinnamomi inoculation when compared with the susceptible
C. sativa [
7]. These previous studies of our group focused on the resistance of chestnut and its response to the Oomycete, indicating that
C. crenata Ginkgobilobin-2-like gene and the encoded protein (Cast_Gnk2-like) might be important in chestnut resistance. In an in vitro tolerance assay with the pathogen
P. cinnamomi, Serrazina, et al. (2022) [
20], observed that transgenic plants of holm oak (
Quercus ilex) with the Cast_Gnk2-like were able to survive longer than non-transgenic ones [
20]. Similar results were obtained in resistance tests against
F. oxysporum in transgenic cucumber (
Cucumis sativus) plants, which showed that the expression of Gnk2-1 conferred antifungal activity against the disease [
25]. Currently, to further demonstrate Cast_Gnk2-like action, the group is working with somatic embryos of
C. sativa lines genetically transformed with the overexpression of the gene. These are being maintained for further assays (studies are still in process).
Other authors have also reported the antimicrobial effects of this protein against many plant and human pathogens [
10,
25]. However, Cast_Gnk2-like was never tested against
P. cinnamomi pathogen to improve the defense focused in Chestnut/
P. cinnamomi pathosystem.
The present work focused on expressing the Cast_Gnk2-like protein and testing its efficacy as a control of
P. cinnamomi. The first step was to optimize the protein expression and test its effectiveness against the pathogen. The recombinant protein expression was performed following different conditions to optimize its process, and the best expression was obtained using the
E. coli strain BL21 (DE3) pLysS. These results are in correspondence to the previous work of Miyakawa et al. (2007) [
26], where the Gnk2 was overexpressed in
E. coli BL21(DE3) using pET-26b and pDsbABCD1 vectors [
25].
Diseases caused by soil-borne pathogens (such as ink disease) are difficult to eradicate, because of their asymptomatic nature during the initial stages of infection and their complex modes of life and dissemination of the pathogens [
27]. The possibility of cure or eradication is very low, and it is, therefore, necessary to develop multidisciplinary strategies to reduce and control them. Farmers depend basically on fungicides to control these diseases. For many years synthetic fungicides were used to control plant production decay. However, public concerns about the harmful effects of chemicals on human health and the environment have caused scientists to search for new alternatives. The incidence of pathogens infections might become more severe in the context of climate change with the possible rise of new strains. For that, it is important to start making more efforts toward these problems [
1].
Currently, we are developing studies and tests for the in-silico protein structure prediction, in vitro 7-day antagonist assays with P. cinnamomi, and metabolomics analysis.
This work re-confirmed that the protein studied has significant potential for biotechnological developments that could reduce the destructive impact of these harmful diseases. Moreover, the Cast_Gnk2-like gene is demonstrated to be a valuable candidate for marker-assisted selection of tolerant C. sativa genotypes. Finally, methods and strategies for the production of antimicrobial phytopharmaceuticals considering Cast_Gnk2-like (pure protein) against P. cinnamomi are also being considered for further research.